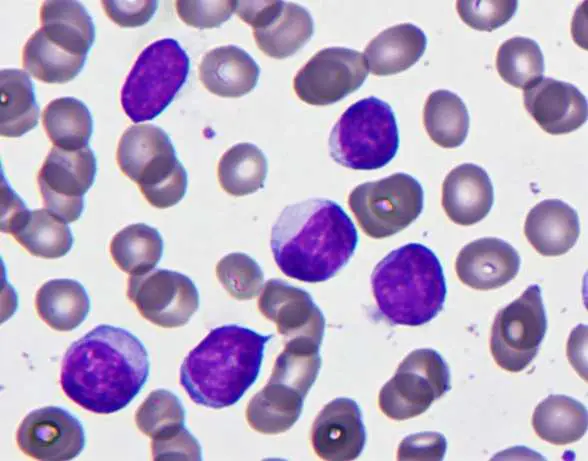
圖片

108年:(醫檢)血液(1)
⼩章最近 臉⾊蒼⽩,醫師發現他⾎中⽩⾎球超標(過⾼),⾎液抹片如下圖。下列何者是最可能的診斷?
ABurkitt lymphoma
BHairy cell leukemia
CChronic lymphocytic leukemia
DAcute promyelocytic leukemia
詳細解析
本題觀念:
慢性淋巴細胞性白血病(chronic lymphocytic leukemia, CLL)是最常見的成人白血病,以成熟小淋巴球大量增生為特徵。血液抹片形態加上臨床表現(白血球過高、臉色蒼白)是初步診斷的關鍵。本題測驗考生從血液抹片辨識 CLL 的典型形態特徵,並與其他淋巴增生性疾病做鑑別診斷。
影像分析:
血液抹片顯示大量體積中等至偏大的淋巴樣細胞,細胞核深染(深紫色),染色質濃縮,核仁不明顯,胞質量少至中等、淡染。這些細胞形態均一,缺乏明顯的核仁或母細胞特徵。背景中可見正常紅血球(呈雙面凹圓盤狀)。整體畫面呈現成熟淋巴球大量增生的型態,符合慢性淋巴球增生性疾病(chronic lymphoproliferative disorder)的特徵。
注意:典型 CLL 抹片通常可見「塗抹細胞(smudge cells / Gumprecht 細胞)」,即因細胞脆弱而在製作抹片過程中破裂的細胞殘影;本片中淋巴球密度高,需結合臨床背景綜合判斷。
選項分析
(A) Burkitt lymphoma Burkitt 淋巴瘤(Burkitt lymphoma)的腫瘤細胞為中等大小、高度均一的母細胞,胞質深嗜鹼性,含有空泡(lipid vacuoles),核仁明顯,細胞增殖極快。骨髓或週邊血液侵犯時(L3-ALL,即 Burkitt
...(解析預覽)...

升級 VIP 解鎖圖文解析